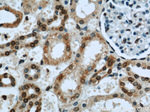
Lamin B1 Antibody in Immunohistochemistry (Paraffin) (IHC (P))

Search
Proteintech
Lamin B1 Polyclonal Antibody
{{$productOrderCtrl.translations['antibody.pdp.commerceCard.promotion.promotions']}}
{{$productOrderCtrl.translations['antibody.pdp.commerceCard.promotion.viewpromo']}}
{{$productOrderCtrl.translations['antibody.pdp.commerceCard.promotion.promocode']}}: {{promo.promoCode}} {{promo.promoTitle}} {{promo.promoDescription}}. {{$productOrderCtrl.translations['antibody.pdp.commerceCard.promotion.learnmore']}}
产品信息
12987-1-AP
种属反应
已发表种属
宿主/亚型
分类
类型
抗原
偶联物
形式
浓度
规格
纯化类型
保存液
内含物
保存条件
运输条件
产品详细信息
Immunogen sequence: EYEYKLAQA LHEMREQHDA QVRLYKEELE QTYHAKLENA RLSSEMNTST VNSAREELME SRMRIESLSS QLSNLQKESR ACLERIQELE DLLAKEKDNS RRMLTDKERE MAEIRDQMQQ QLNDYEQLLD VKLALDMEIS AYRKLLQGEE ERLKLSPSPS SRVTVSRASS SRSVRTTRGK RKRVDVEESE ASSSVSISHS ASATGNVCIE EIDVDGKFIR LKNTSEQDQP MGGWEMIRKI GDTSVSYKYT SRYVLKAGQT VTIWAANAGV TASPPTDLIW KNQNSWGTGE DVKVILKNSQ GEEVAQRSTV FKTTIPEEEE EEEEAAGVVV EEELFHQQGT PRASNRSCAI M (237-587 aa encoded by BC012295)
靶标信息
Lamin B1 is a key member of the nuclear lamina structure, encoded by the LMNB1 gene. It is part of the B-type lamins, ubiquitously expressed across all mammalian cells, providing structural integrity and mechanical support by forming a meshwork along the inner nuclear membrane. Lamin B1 is involved in maintaining the shape and stability of the nucleus, playing a critical role in cellular processes such as genome organization, DNA replication, and transcription regulation. The lamin filaments are type V intermediate filament proteins, enabling the nucleus to withstand mechanical stress and preserve its functionality. Lamin B1's expression and dynamics vary during cell differentiation, influencing gene regulation. Its location within the euchromatin-enriched section of the genome suggests potential roles in chromatin organization and the epithelial-to-mesenchymal transition. Governed by complex interactions with other proteins, lamin B1 is integral to cellular architecture and health, with variations in its levels linked to developmental and disease processes. Recent studies have highlighted the importance of understanding the role and dynamics of lamin B1 in human-induced pluripotent stem cells and germ layer cells, offering insights into differentiation-dependent changes and their implications for nuclear structure.
仅用于科研。不用于诊断过程。未经明确授权不得转售。
生物信息学
蛋白别名: lamin B; Lamin-B1; MGC111419; unnamed protein product
基因别名: ADLD; ADLDAT; LMN; LMN2; LMNB; LMNB1; MCPH26
UniProt ID: (Human) P20700, (Mouse) P14733, (Rat) P70615
Entrez Gene ID: (Human) 4001, (Mouse) 16906, (Rat) 116685